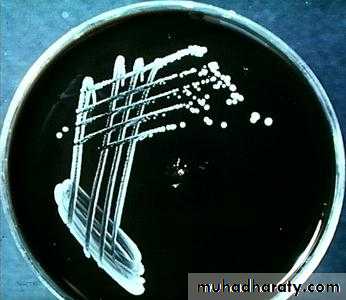

Bordetella pertussis
http://www.hhmi.princeton.edu/sw/2002/psidelsk/Microlinks.htm
Whooping CoughAlso known as Pertussis
Outbreaks first described in the 16th Century
Major cause of childhood fatality prior to vaccination
paaap.org/immunize/ course/slide27.html
PertussisHighly contagious respiratory infection caused by Bordetella pertussis
Outbreaks first described in 16th century
Bordetella pertussis isolated in 1906
Estimated >300,000 deaths annually worldwide
Pertussis Pathogenesis
Attachment to cilia of ciliated epithelial cells in respiratory tract
Pertussis antigens allow evasion of host defenses (lymphocytosis but impaired chemotaxis)
Local tissue damage in respiratory tractSystemic disease may be toxin mediated
Pertussis Clinical FeaturesIncubation period 5-10 days (up to 21 days)
Insidious onset, similar to minor upper respiratory infection with nonspecific cough
Fever usually minimal throughout coursePertussis Clinical Features
Catarrhal stage 1-2 weeksParoxysmalcough stage 1-6 weeks
Convalescence Weeks to months
Pertussis in Adults
Accounts for up to 7% of cough illnesses per yearDisease often milder than in infants and children
Adults often source of infection for children
Pertussis Complications*
Condition
Pneumonia
SeizuresEncephalopathy
Death
Hospitalization
Percent reported
5.2
0.8
0.1
0.2
20
*Cases reported to CDC 1997-2000 (N=28,187)
Pertussis Epidemiology
Reservoir HumanAdolescents and adults
Transmission Respiratory droplets
Airborne rare
Communicability Maximum in catarrhal stage
Secondary attack rate
up to 90%
Diagnosis
Isolation by culture
PCR
Direct fluorescent antibody
Serological testing
http://medinfo.ufl.edu/year2/mmid/bms5300/images/d7053.jpg
TreatmentAntibiotic therapy
Erythromycin
Azithromycin and clarithromycin
http://www.aboutthatbug.com/AboutThatBug/files/CCLIBRARYFILES/
FILENAME/0000000032/033_lg.jpghttp://www.vet.purdue.edu/bms/courses/lcme510/chmrx/macrohd.htm
Prevention
The primary method of prevention for pertussis is vaccination. There is insufficient evidence to determine the effectiveness of antibiotics in those who have been exposed but are without symptoms. Preventative antibiotics, however, are still frequently used in those who have been exposed and are at high risk of severe disease (such as infants).